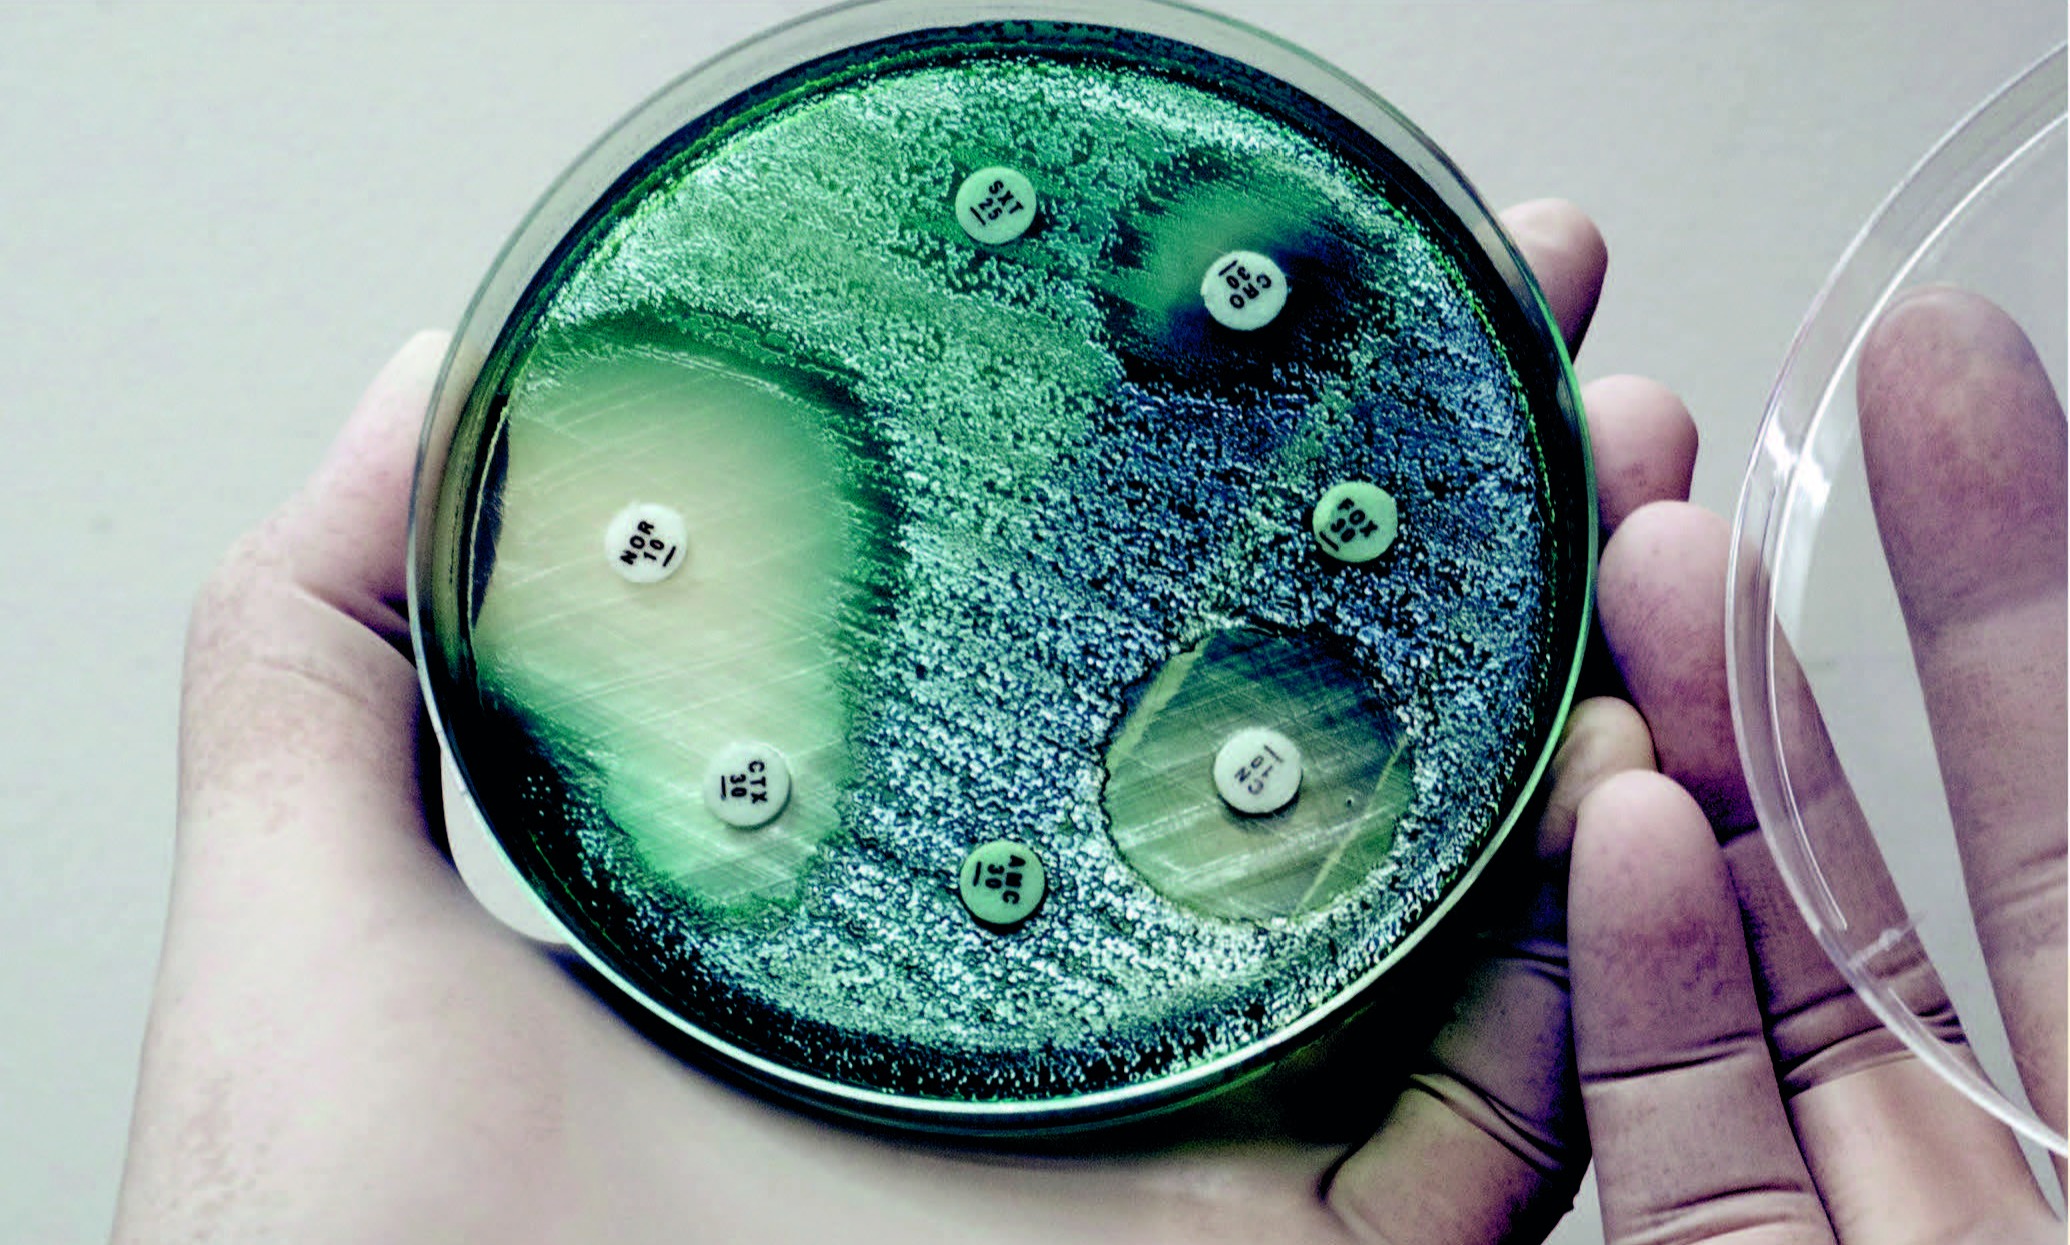
Drug History Lectures with Claas Kirchhelle

This project investigates the history of pharmaceutical markets for children across the twentieth and twenty-first centuries. While there is a considerable body of scholarship on the clinical use, administrative regulation and scientific marketing of pharmaceuticals in adults, children have so far only received scarce attention. This a considerable omission since pediatric uses of pharmaceuticals have distinct clinical, political and economic dynamics that ask for different narratives than those established for adult medicine. This project seeks to provide such narratives focusing on Switzerland as an exemplary case.
Methodologically, the project follows a collaborative case study approach with three interrelated analytic levels. The ‘micro-level’ reconstructs prescription practices in pediatric hospitals based on an investigation of medical files (1920s-1990s. It investigates the interplay between pediatric practice and the evolving pharmaceutical market with case studies of pediatric diseases (Frédéric Mader and Camille Koch).
The ‘meso-level’ traces the history of pediatric drug development, marketing, regulation, and policy in Switzerland, drawing on archival material, oral history, legal texts, professional journals, and the popular press (Felix E. Rietmann). It explores how pediatric pharmaceutical markets have been created through both political regulations and marketing efforts and how children have been framed as consumers of medications.
The ‘macro-level’ investigates the global entanglement of Swiss drug use, policy and trade. It situates Swiss medical and regulatory practice in an international political landscape and on a global market (Paul Turberg). Finally, the project includes a transversal collaborative component that traces the trajectory of selected pharmaceuticals from local practice to regulatory politics and global trade.
Situated at the intersections of the history of childhood, the history of medicine, and economic and political history, the project aims at a better understanding of the roles and lives of children in our evolving pharmaceutical landscape. It will provide a model for future studies of structural transformations in children’s health, health policy, and the pharmaceutical market across the twentieth and twenty-first centuries.
News
-
Drug History Lectures with Claas Kirchhelle
On the 28th of May 2026, Prof. Claas Krichhelle will give the first talk of the drug history lectures entitled “How Antibiotic Innovation became a Market Failure (1980-2024).”
